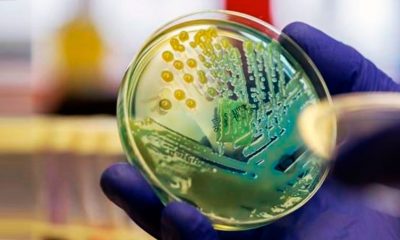
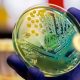
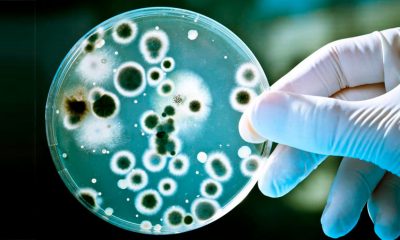
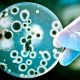

Estudo da Fundação Oswaldo Cruz (Fiocruz) aponta que o aumento do número de casos e internações por covid-19 em vários estados que vem sendo registrado desde...



Dois homens foram encontrados mortos, com marcas de tiros no corpo, nesta quinta-feira, 10, no bairro de Cajazeiras. Após denúncia feita para o 190, uma equipe...

A Agência Nacional de Vigilância Sanitária (Anvisa) emitiu um alerta ontem (7) sobre uma investigação do primeiro caso positivo no país de Candida auris, fungo resistente...



A Prefeitura já conta com toda estratégia e a estrutura necessária para iniciar a vacinação contra a Covid-19 na capital. Para viabilizar de forma mais ágil...

Identificado pela primeira vez no ouvido de uma mulher japonesa em 2009, o Candida Auris é um fungo emergente de difícil diagnóstico que vem se espalhando pelo...



Entra em vigor nesta quarta-feira (9) o decreto que suspende por 14 dias o funcionamento de bares e restaurantes nos bairros do Rio Vermelho e Itapuã,...



Uma agência da Caixa Econômica Federal foi atacada na madrugada desta terça-feira, 8, na rua Genaro de Carvalho, no bairro de Castelo Branco, em Salvador. De...



Nesta segunda-feira (7), o governador Rui Costa comentou o aumento do número de óbitos e classificou que a Bahia está vivendo uma segunda onda da...